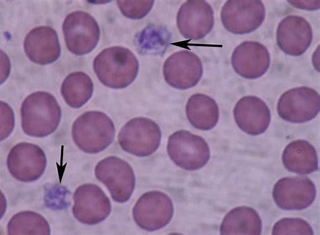

PLAQUETAS
17.05.2018
Son los elementos más pequeños de la sangre, y resultan esenciales para la coagulación sanguínea, ya que se encargan de cerrar los vasos sanguíneos, haciendo que la sangre se coagule para taponar las lesiones cuando se produce una herida.